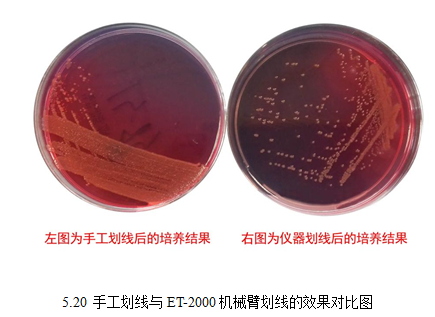

【CAIVD蓝皮书】微生物检测(二)
更新时间:2017/7/5 16:11:51 浏览次数:10362第四节 临床微生物检测的自动化
一、 概述
传统的微生物诊断主要包括病原菌的培养、鉴定、药敏试验,耗时较长无法满足临床对快速诊断的需求。近年来,随着人口老龄化、慢性病人群增加,各类感染易于发生、耐药菌株流行,使临床微生物标本量增多,临床微生物标本检测量以每年10%~15%的速度递增。随着循证医学的发展,医生对实验室检测的依赖性显著提高,要求更多、更快、更精准的项目指导诊断和治疗;基质辅助激光解析电离飞行时间质谱(matrix-assisted laser desorption ionization-time of flight mass spectroscopy,MALDI-TOF MS)、液基微生物学、数字成像系统、实验室信息学等技术成为现实临床微生物全实验室自动化的重要元素;全实验室自动化能够提高检测质量、减少出错率、提高实验室效率和效能,成为现代实验室追求的标准。临床微生物标本类型复杂,大多实验室并未使用条码系统,如果在接收标本、接种标本、培养标本、鉴定标本的任一环节出错,都会导致结果出错。这一系列的因素,推动了临床微生物自动化。
二、当前临床微生物检测的自动化进展
目前,临床微生物检测的自动化主要以分析前的标本处理、接种或分液和加样、分析中的孵育及数字成像和分析后的数据管理系统为主。
1、分析前的标本前处理自动化设备 厦门信道生物技术有限公司的标本液化处理仪系列(图5.10)采用Sciendox独家专利——全过滤标本处理技术的台式标本液化处理仪,可将部分固态、半固态标本处理成适合浓度的应用液。仪器配备标本转盘,适合批量处理标本。标本转盘:一次可放20个标本,混匀次数0~99次,并可根据不同标本性状调整,加液量:0.1~10毫升,标本有专用样本瓶,可在不开盖的条件下进行个性化处理,每个标本均可单独选择处理模式。同时采用不堵孔技术,避免过滤时堵孔。可处理的标本包括:粪便、痰液、分泌物、其他体液、部分肌肉组织等。
2、

图5.10 Sciendox-2A 型
2、分析前的自动化分液和加样设备 国产化微生物检测的自动化分液和加样、接种设备在近两年有了突飞猛进的发展,一大批自动化分液和加样、接种设备涌入市场,推动着微生物检测行业的自动化发展。
珠海市银科医学工程股份有限公司在新推出两款加样机,分别是YK-96小型全自动移液平台,见图5.11,和YK-009自动化加样判读一体机,见图5.12。
YK-96小型全自动移液平台特点是自动化加样可减少人为误差、提高精准度;智能化选择,适合MicroDST全系列产品;加样时间短,3至5分钟完成96孔微孔板的加样;占用空间小,可置于生物安全柜内。
YK-009自动化加样判读一体机适用于该公司生产的支原体鉴定药敏试剂盒(培养法)的加样和培养结果的判读、记录、保存、输出检验结果数据及打印检验报告单。适用于不同型号支原体药敏测定板的加样及结果判读包括26孔、28孔和40孔。

湖南长沙天地人生物科技有限公司的TDR-J100自动加样仪(图5.13),该仪器的特点是:(1)自动运行:可以自动完成鉴定药敏试验卡的液体分配工作,并可自动移除吸样枪头,简捷易用。(2)加样精准:TDR-J100自动加样器采用单臂旋转式设计,能够精准完成试验卡的加样,每孔加样量CV值<5%。(3)基本参数:准确性:(150±15)μL;重复性:CV<5%;适用产品:TDR系列鉴定药敏试验卡;环境温度:10℃~30℃;相对湿度:35%~80%RH。

珠海迪尔生物工程有限公司的SCAN-10自动加样仪(图5.14),利用微电脑程序控制进行加样,减少人为疏忽出现的少加、漏加及多加的现象。该仪器轻便灵活、适应性强、性能稳定,能够满足广大型实验客户的需求。

珠海市银科医学工程股份有限公司、珠海丽珠试剂股份有限公司、郑州安图生物股份有限公司分别推出的药敏加样器(见图5.15),分别与各自公司生产的支原体鉴定药敏试剂盒配套使用,适用于不同型号支原体药敏测定板的加样,以减少繁琐的加样操作。

3、分析前的自动化接种设备 自动化的平板接种仪是一种用于划线接种培养基的革命性突破,以机器取代人工繁琐复杂的操作,无需人工干预,提高了生物安全性。液体基质标本基本上都使用法国生物梅里埃的PREVI-Isola,针对固态标本常使用美国BD公司的inoqulA,还有WASP和Innova。
贝克曼库尔特公司的WASP微生物样本前处理系统见图5.16,该产品的特点是完整的自动化:WASP是能实现微生物样本前处理的所有关键步骤自动化的机器人,包括接种划线、革兰玻片制备、增菌肉汤接种以及药敏纸片分配等;无需更改的工作流程:金属接种环接种与手工接机完全一致,提供多种划线模式,也可以自定义划线模式,根据不同的标本类型,能自动更换接种针1μL,5μL,10μL,30μL;快速高效的处理流程:全电驱仿真机械臂配合线性的台式设计和机械动态取放,能达到更佳的工作效率;准确可靠的结果:实时扫描保证样本处理的每一步都可追溯。内置高速漩涡混匀系统,保证接种前样本均匀;灵活开放的实验平台:全模块化设计,支持自定义轨道、培养箱、数字影像模块等。

重庆江雪科技有限公司的全自动螺旋接种仪(图5.17),主要原理是将平板置于螺旋接种仪的转盘上,加样器吸取待测菌悬液后,接触培养皿中心琼脂表面,在平皿旋转的同时,加样针从平皿中心向一侧运动,并将菌悬液接种到琼脂表面。接种后,培养出来的菌落依据阿基米德螺线分布,并随半径的增加分布得越来越分散。

武汉迪艾斯科技有限公司自主研发并具有独立知识产权的自动化细菌分离培养系统、自动化微生物样本前处理系统、新型全自动血培养系统、自动转种式血液培养系统、全自动动态血沉分析系统等产品。其中自动化微生物样本前处理系统(图5.18),集样本预处理、划线接种与分离培养一体化完成;专利结构设计符合ISO15189的要求;独立的普通、苛养、真菌培养环境;拥有专利样本均质化采集管,有效防止气溶胶播散;划线接种后样本池自动退出功能。

济南百博生物技术股份有限公司产品微生物样本处理智能机器人ET-2000(图5.19),解决了微生物实验室的接种分离工作对人的依赖,提高了微生物实验室的工作效率,最大限度地将医务人员从繁重的体力劳动中解脱出来,并且极大的保护了医务人员的免受病菌感染,是国内微生物领域的一项革命性的突破,是国内首台真正意义上的全自动微生物样本处理智能机器人,并分别在中国智能制造国际高峰论坛暨中国智能产业创新创业大会上荣获优秀项目“三等奖”,在2016“创之声”第一届中国实验医学大会(CCEM)上荣获2016年度“创之星”杯中国实验医学年度创新产品“三等奖”是微生物领域的一项重大创新。

ET-2000采用水平多关节机器人模仿人工划线接种,并具备自动记忆功能。接种划线轨迹可根据不同要求私人定制。自动蘸取样本进行划线并且可以自动消毒。可以针对不同标本,进行不同模式的划线选择,主要有三区划线(图5.20)、四区划线、丰字划线、螺旋划线等等多种划线模式。该机器人采用傻瓜式智能式设计,整个运行过程无需人工干预。机器人会根据样本条码信息,自动分配需要的各种不同培养基,整个过程会自动完成读码、打码、贴标、样本搬运、培养基搬运、开盖、旋盖、取样、划线接种、消毒等一系列相关流程。运行过程出现异常,会有声光报警提醒。该机器人最大的亮点,是采用了百博公司独有的视觉技术,可以在显示器上实时的显示内部样本的处理进程,给工作人员带来了极大的直观性和方便性。
4、分析中的自动化孵育系统 分析过程中用到的自动化设备主要是微生物培养过程中所用到的,目前我国自主研发生产的该类设备较少,主要还是依赖进口。
国产自动化孵育系统:国内微生物检测分析中用到的自动化孵育系统较少,其中最具代表的是迪艾斯科技的智能化微生物培养系统,该设备可设置普通培养环境和苛氧培养环境;动态显示培养板细菌生长情况;细菌生长状态提示;建立细菌生长数据库等优势,外形见图5.21。
珠海迪尔生物工程有限公司的B群链球菌培养分析系统通过将已接种的培养基放入检测系统中,在37℃恒温环境下持续培养,培养基为B群链球菌生长繁殖提供较高的营养成份及生长因子,同时抑制部分杂菌的生长, B群链球菌在培养过程中使培养基底部发生颜色变化。培养分析系统利用光学传感器连续监测培养基底部颜色的变化,从而判定待检标本的阴阳性结果。见图5.22。

进口自动化孵育系统:目前用于临床微生物的自动化孵育设备主要还是依赖进口。
美国伯腾仪器有限公司(BioTek Instruments, Inc.)是一家集开发,生产和销售微孔板相关仪器及分析软件于一体的公司,成立于1968年,总部位于美国的佛蒙特州,是该行业的领先者。为全球用户提供最顶级的微孔板检测相关设备和软件。该公司的BioSpa 8自动化孵育器可以与BioTek的检测仪/成像仪或洗板/分液器相互对接,完成全自动工作流程,板处理通量可达8块板。实时监控和持续的温度、CO2/O2和湿度水平控制, 并具有板盖处理功能,保证了实验所有阶段的细胞培养可具有理想化环境。同时该设备还可对温度、湿度和气体进行灵敏监控,非常适合长短期的细胞/细菌研究分析。数字成像系统可在任何时间读板,并可储存在不同时间读取的图像,同时,细菌仍在培养箱中生长,直至恰当的状态而进入下一步骤。因此,可节省时间、随时检测菌落生长状态、提高质量控制水平。见图5.23。

贝克曼库尔特公司的WASP-LAB轨道与智能培养箱见图5.24,该设备的特点是高容量:包括两个型号——可存放854个或者1708个培养皿,支持普通培养与CO2培养;能自动装载与卸载平板;条码能自动阅读与自动检索;提供更加优化的生长条件;存取平板无需开门,保证CO2浓度维持稳定及温度稳定;平板自动倒置培养;数字化管理平板信息。

英国的sensititre(先德)荧光法速微生物药敏及鉴定分析系统,ARIS 2X主机系统由全自动孵育器和自动读数系统组成,减少了工作量,提高了实验室常规试验的效率。生产该类产品还有美国BioMerieux 公司、英国Ttrek Diagnosetic Systems公司、法国生物梅里埃公司的全自动细菌/分枝杆菌培养检测系统和美国GILES Sciencific公司。
5、分析后的细菌鉴定和药敏分析系统 良好的数据管理,可更好地对鉴定和药敏结果上报临床,美国BD公司推出的数据管理软件BDEpicenterTM,在细菌鉴定和药敏结果出来后,可以不依赖微生物实验室发放报告,软件系统直接整合患者的检验结果,临床医生在工作站可马上获取结果。对于危急值结果,甚至可将结果直接推送到临床医生的手机上,可自动去除重复的数据进行流行病学分析。生物梅里埃的Myla对于危急值结果也可通过短信、网络报警灯的方式进行发布与远程警报,对多重耐药菌和血培养污染菌进行分析跟踪。
国产的设备:近几年国内已有不少厂家生产了鉴定药敏分析系统,具体有珠海美华医疗科技有限公司、上海星佰生技术有限公司、珠海迪尔生物工程有限公司、山东鑫科生物科技股份有限公司、合肥微星生物科技有限公司、湖南长沙天地人生物科技有限公司、江苏三联生物工程有限公司等。
其中珠海美华医疗科技有限公司的微生物鉴定药敏分析系统,该设备可以鉴定细菌包括:肠杆菌科、非发酵菌科、葡萄球菌/微球菌科、链球菌/肠球菌及酵母样真菌属等,近500种细菌(或真菌)。还可连接HIS系统、WHO推荐的WHONET5系统。见图5.25。

2016年珠海迪尔生物推出了全自动细菌鉴定药敏分析系统——96A细菌测定系统,能自动添加各类辅助试剂,能自动快速的出具鉴定药敏报告,拥有良好的联网功能和拓展功能。
6、分析后的自动化血培养设备:国产的自动化血培养设备研制厂家主要有:合肥恒星科技开发有限公司、山东鑫科生物科技股份有限公司、索微生物技术(苏州)有限公司、北京伯盛泰科技有限公司、珠海美华医疗科技有限公司、安图生物和珠海迪尔生物工程有限公司等。
合肥恒星科技开发有限公司生产的全自动血培养仪(图5.26)及其配套培养瓶是与中国科大、安徽省立医院、安徽医大附一院等合作开发的项目;是安徽省“十五”重点科技公关项目,荣获安徽省科技成果奖,其中抗生素药敏试验专家系统填补了国内空白。

山东鑫科生物科技股份有限公司的自动血培养仪(图5.27)是国际上第三家掌握其核心技术的企业。自动血培养仪的培养瓶种类齐全,营养条件适合各种细菌生长,提高阳性报警率;光学检测+瓶底显色,两种技术同时使用,极大降低标本的假阴性。生长曲线全程动态实时显示,智能分析,精确判断,48小时内阳性标本报警率90%以上,支持标本延迟上机等功能。

安图生物全自动血培养系统(图5.28)采用先进的非侵入和可视化技术,配合独特的光学检测系统,实现血培养检测的全面自动化;使用稳定的温控系统和可靠的震荡模式,大大缩短血培养的报阳时间,降低了假阳性率,达到了国际先进水平。该设备操作方便、占用空间小、信息实时显示、定时检测,自动绘制生长曲线、 最短3小时内即可出培养结果等优点。

珠海迪尔生物工程有限公司的全自动血培养系统(图5.29)采用非侵入性检测原理,利用CO2传感器检测是否有微生物生长,并通过光电探测器测量光的变化以及多种模式的数学运算分析,准确得出微生物生长状况。可检测血液或各种无菌体液标本。该设备的特点是:①连续摆动培养,自动检测,自动校正,自动存储信息。64个孔位每孔具有独立检测器,每十分钟检测一次,提高检测速度和准确率;②声、光、色三级报警功能,第一时间提醒细菌生长状况,支持48小时延时上级功能;③模块化结构,方便扩展;④采用windows系统,彩色触摸屏,电脑主机及培养箱一体式人体工程学设计,适应潮流,美观大方配备条形码扫描仪和键盘,运行过程中随时取瓶及置瓶,特殊提醒功能避免操作失误及错置瓶;⑤90%阳性结果在24小时内报阳性、98%阳性结果在48小时内报阳性。保证最低的假阴性率和假阳性率;⑥同时可提供DL-Bt32,DL-Bt64,DL-Bt1122,DL-Bt224,DL-Bt336等多种型号选择。

索微生物技术(苏州)有限公司的SW-ABCS-60型血培养系统(图5.30),主要利用微生物代谢产物CO2等气体的改变,经特殊传感器并由光电探测器测量光的变化,采用不同菌种独立数字模型、专利计算软件对光信号进行分析而准掌握微生物生长状况,适用于对接种有疑似菌血症、真菌血症、分枝杆菌血症患者样本的培养基进行孵育、摇匀和连续监测,可快速、智能的培养和检测临床标本中的细菌和真菌。

7、其他微生物自动化设备 除了以上提到的微生物检测仪器以外,在临床中还用到的设备主要是:全自动菌落计数器(仪)、自动痰涂片染色机和自动化血培养设备等。
全自动菌落计数器(仪):全自动菌落计数器(仪)利用其强大软件图像处理功能和科学的数学分析方法对微生物菌落分析和微颗粒粒度进行检测,适合医院、科研院所、卫生防疫站、疾病控制中心、检验检疫、质量技术监督、环境检测机构以及制药、食品饮料、医疗卫生用品行业等的微生物检测。目前国内自主研发生产的自动菌落计数器包括有广州环凯微生物科技有限公司、北京麦思奇高科技有限公司、上海海恒机电仪表有限公司、杭州迅数科技有限公司、青岛众瑞智能仪器有限责任公司等公司。进口的品牌则包括有美国贝克曼、法国interscience、美国BD公司、英国synbiosis、英国Sorcere等。
北京麦思奇高科技有限公司研制生产的的菌落计数器是一种数字显示式自动细菌检验仪器。由计数器、探笔、计数池等部分组成,计数器采用CMOS集成电路精心设计,LED数码管显示,字高13mm,清晰明亮,配合专用探笔,计数灵敏准确。菌落对比清楚。便于观察。见图5.31。
自动痰涂片染色机:襄阳科瑞杰医疗器械有限公司的自动痰涂片染色机 KRJ/TTR2-36(图5.32),主要用于对已制成的痰涂片样本进行抗酸染色、荧光染色、革兰染色等,主要特点如下:
1)自动涂片功能:专用仪器标本杯可自动进样、自动开盖、自动取样、自动涂片、自动关盖;
2)自动制片功能:采用纳米表面处理技术和恒温控制技术,自动完成涂片的烘干固定;
3)自动染色功能:自动完成涂片的染色、脱色、复染、水洗、风干;
4)自动负压装置:内部负压设计。排气经过高效过滤,符合国家生物安全要求。

8、非培养法的微生物自动检测设备:自动化白带分析仪
传统的BV检测主要还是依靠手工操作来完成,但随着BV检测项目的不断增多,操作及结果判断越来越复杂,分泌物检测也在将逐步的往半自动化、自动化的方向发展。 尤其在2015年至2016年,自动化的白带分析仪在临床需求的推动下迅速发展。
江苏硕世生物科技有限公司创立于2010年,公司拥有多重荧光定量PCR、生物芯片、酶化学等现代生物学技术平台,从事传染性疾病、遗传性疾病、食品安全及肿瘤等领域的产品研发、生产及销售。其阴道微生态评价系统(图5.33)利用干化学酶法实现的对特定病原菌产生的特异性酶的检测,同时外置配备了显微镜成像系统,完整的呈现分泌物标本的微生物学形态,帮助用户对阴道微生态进行整体评价。

丽拓生物是专业从事临床诊断试剂与医疗仪器,集研发、生产、销售于一体的国家高新技术企业。丽拓生物创建于2000年,现旗下拥有珠海市丽拓发展有限公司、湖南省丽拓生物科技有限公司。其中自主研发的产品LTS-V400阴道炎检测仪(图5.34)已获得发明专利。

广州江元医疗科技有限公司的 AT-1600全自动细菌性阴道病(BV)检测仪(图5.35)采用光学反射加色和减色法原理设计,是集温育、加样、检测、结果计算、判断、显示、清洗、报告输出等步骤全部自动化的实验室检测仪器。

郑州安图生物工程股份有限公司的woMO联检分析仪(图5.36)为该公司生产的《阴道炎五联检》专用分析仪,带有自动测量、分析、打印测定结果的功能,一次可检测5份标本,可存储检测信息4000份,带有内置热敏打印功能、可外接计算机无限扩容。

重庆天海医疗设备有限公司的BD-500全自动白带检测分析仪,见图5.37,充分发挥其在影像学成像系统方面的技术优势,全国首家创造性的将形态学与酶化学进行一体化应用,真正实现自动化的液体活检、操作自动化、结果自动判读的一体化,在形态学检测上采用一次性光学玻璃计数板,可选择性进行染色或直接涂片检测,具有自动聚焦及细胞跟踪技术。
其他还有山东麦田生物技术有限公司自主研发生产的全自动阴道炎检测仪(MT-1000/2000/3000/4000/5000/6000)(图5.38)以及珠海科域生物工程有限公司、厦门信道等公司均在进行自动化白带分析仪的研制。

图5.38 全自动阴道炎检测仪(MT-1000/2000/3000/4000/5000/6000)
三、小结
放眼我国近几年来微生物检测的发展趋势,国产的自动化、智能化的临床微生物样本、鉴定系统逐渐全面,即使是以往认为很难实现的样本前处理系统也开始在向自动化发展方向迈进。济南百博生物技术股份有限公司2016年成功研制出的微生物样本处理智能机器人ET-2000,并且2017年1月正式装机成功,这是我国医疗器械业内的一大进步,还有迪艾特科技智能化微生物培养系统、珠海银科医学新推出的YK-96小型全自动移液平台和湖南长沙天地人生物科技有限公司的TDR-J100自动加样仪等自动化设备的成功开发和推广,说明了临床微生物检测走向自动化、智能化的必然性。
(孙宜峰 曾冰冰 王妹)
第五节 总结与展望
2016年是对医疗器械行业而言是不平凡的一年,是注定载入历史的一年,各种新政策法规层出不穷,国家监管形式日趋严峻,医疗器械飞行检查、日常监督抽查、临床试验核查、冷链运输管理等各种监督管理手段让生产和经营企业都应接不暇,两票制的出台更是导致了整个行业格局的大变化,传统的经营模式已不再适合企业的发展,而传统微生物检测技术微薄的利润空间被严重的挤压,在严峻的监管态势和运营成本的高压态势下,传统的基于手工操作的微生物检测技术将逐渐走下坡路,正逐渐被POCT技术、分子诊断、流式细胞检测、质谱检测、二代测序等系统化、自动化、精准化、效率化的检测技术所取代。传统的临床微生物检测产品需要在自动化、智能化的操作和分析设备、软件以及创新性应用等方面寻找新的出路。而特殊的微生物检测产品,例如基于表型药敏检测的微生物检测技术、具有选择性、初步鉴定功能的功能培养基(例如显色培养基)目前仍然具有一定的市场前景。
扫描下载体外诊断头条APP
扫描关注CAIVD官方微信
扫描关注CAIVD官方视频号
扫描关注CACLP官方微信
扫描关注CACLP官方视频号
全国卫生产业企业管理协会实验医学分会
( 京ICP备15010734号-10 )



